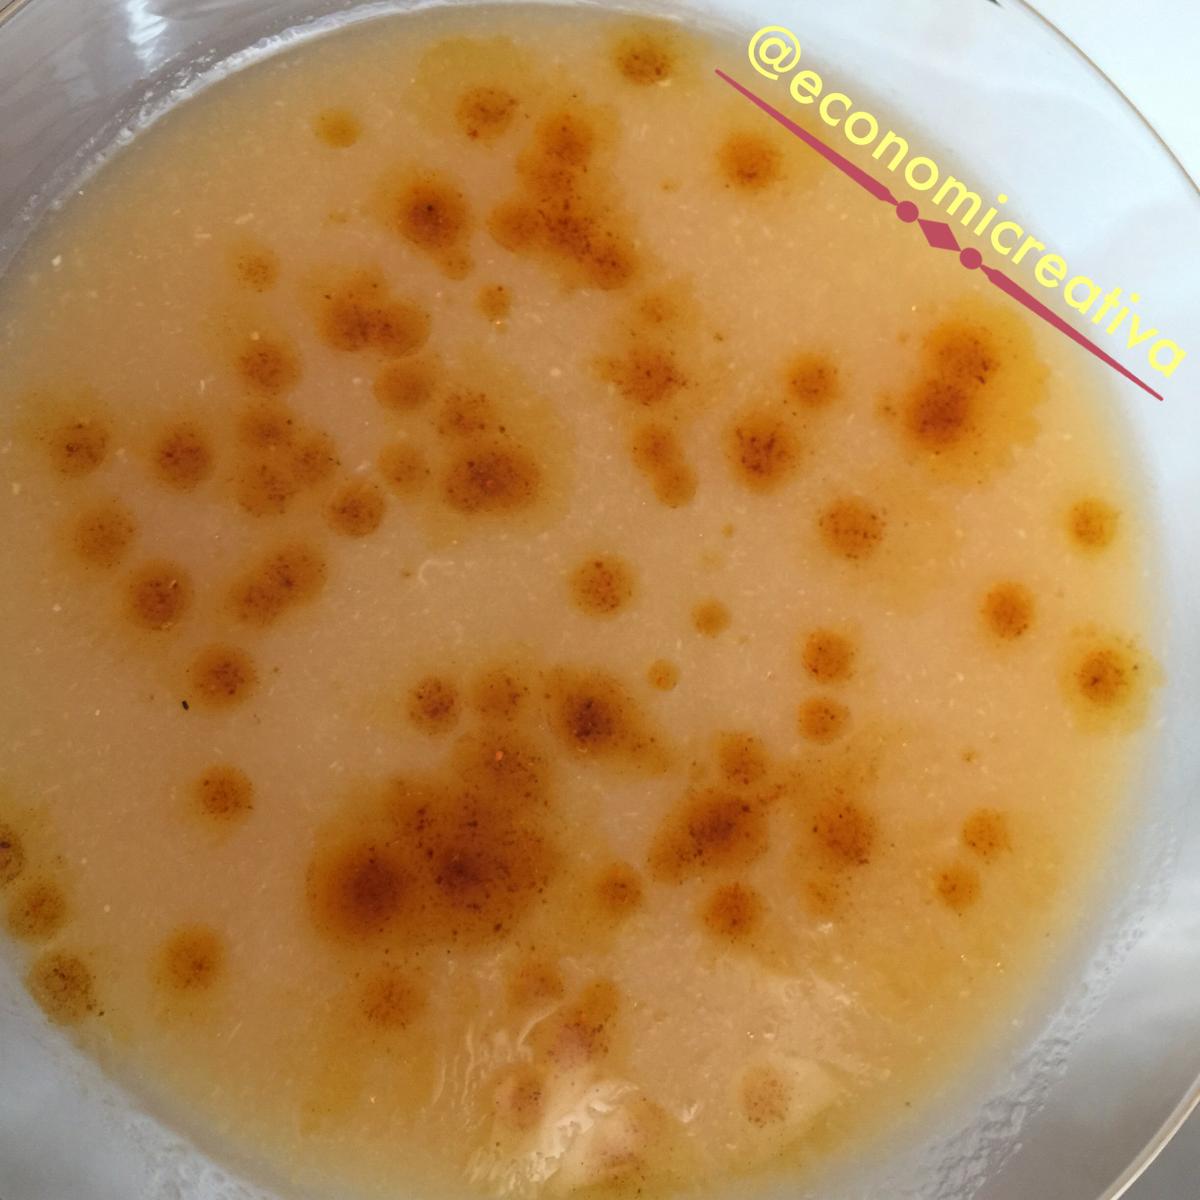
Crema fría de calabacín y limón

Esta crema fría de calabacín y limón ha surgido como casi todas mis recetas, de casualidad, y la verdad es que el resultado es ¡sorprendente!
Crema fría de calabacín y limón – Ingredientes
2 calabacines
2 puerros
1/2 tomate
1 limón
1 litro de agua
sal
aceite de oliva virgen extra
pimentón dulce
Crema fría de calabacín y limón – Preparación
Se pone a calentar agua. Yo he utilizado la olla programable GM modelo B.
Se pela el calabacín y se trocea en rodajas de 1 cm. Se reserva
Se limpia el puerro y se trocea igual que el calabacín.
Se lava el tomate y se corta en cuartos.
Se lava el limón, se le quitan los extremos y lo partimos, primero por la mitad y cada mitad en 4 cuartos.
Una vez empieza a hervir el agua, se agrega sal al gusto y las verduras que se han preparado con anterioridad.
Cuando termina el programa, se tritura todo. Después se pasa por el chino para quitar pieles y restos que pueden resultar desagradables al paladar.
Se deja enfriar.
A la hora de servir, mezclamos 4 cucharadas de aceite de oliva virgen extra con media cucharadita de pimentón dulce. Se introduce en el microondas medio minuto a máxima potencia para cocinar ligeramente el pimentón.
Se sirve la crema fría de calabacín y limón y se ponen unas gotas de aceite con pimentón.
Y… ¡Aquí está el resultado!
The post appeared first on Recetas Económicas y Creativas.